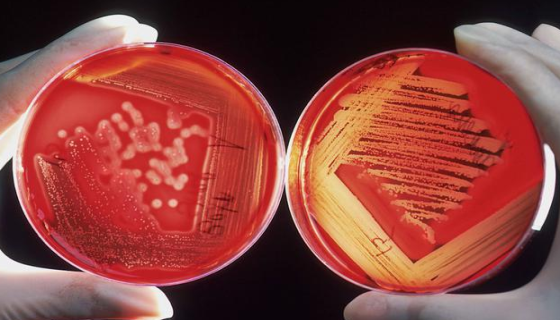
甘露醇卵黄培养基基础在食品行业的具体应用场景有哪些？

甘露醇卵黄培养基基础在食品行业的具体应用场景有哪些?
甘露醇卵黄培养基基础在食品行业的核心应用是针对性检测食源性致...

兔原代大隐静脉内皮细胞的培养过程中需要注意哪些事项?
兔原代大隐静脉内皮细胞的培养成功率较低,核心注意事项围绕无菌...

人肾皮质近曲小管上皮细胞体外培养过程中需要注意的事项!
人肾皮质近曲小管上皮细胞体外培养的核心是维持细胞的原代表型和...

金氏B培养基的使用注意事项有哪些?体现在哪些方面?
金氏B培养基是假单胞菌荧光素检测的专用培养基,其使用效果直接...

大肠埃希氏菌的抗原构造及其在临床诊断中有哪些应用?
大肠埃希氏菌的O、H、K 抗原分型是临床诊断中鉴别菌株致病性...

蛋白胨山梨醇胆盐肉汤培养基的成分与作用原理及实验现象!
蛋白胨山梨醇胆盐肉汤是一种选择性增菌培养基,主要用于大肠埃希...

卫矛醇半固体生化管接种的常见失误与解决方案及注意事项!
卫矛醇半固体生化管主要用于细菌的卫矛醇发酵试验和动力检测,接...

细胞系培养小鼠肾小管上皮细胞的应用领域及注意事项有哪些?
细胞系培养的小鼠肾小管上皮细胞因增殖稳定、均一性高、操作便捷...

小鼠肾上腺皮质瘤细胞的培养过程中需要注意哪些事项?
小鼠肾上腺皮质瘤细胞的培养需重点关注贴壁特性、激素敏感性及污...